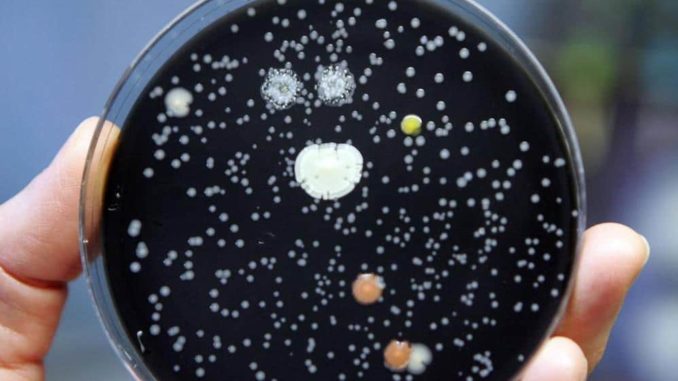

![]()
Cresce ancora il numero dei contagiati dal batterio che ha fatto tre morti nel comune alle porte di Milano. Alla ricerca della sorgente del contagio. Lo Sportello dei diritti “Poca prevenzione, ovunque ci sia acqua calda c’è pericolo di trovare il batterio”. Stando a quanto riportato dai dati dell’ ECDC sulle malattie infettive in crescita esponenziale gli ammalati di “legionellosi” nella UE. Mai tanti dal 2014.
Sale ancora il numero delle persone contagiate da legionella a Bresso, vicino a Milano. Tra venerdì e sabato sera sono stati registrati altri sette casi. Sale così a 40 il numero totale delle persone in cura perché hanno sviluppato la malattia respiratoria provocata dal batterio, che all’inizio della settimana aveva provocato il decesso di tre anziani. Nonostante l’allerta rimanga alta, la situazione clinica dei malati non risulta essere preoccupante. Tutti i pazienti, affermano i medici, sono stabili o in fase di remissione. Intanto nella cittadina lombarda proseguono i controlli alla ricerca delle sorgenti del batterio della legionella, anche ai luoghi di aggregazione, come ad esempio, poste, banche o centri commerciali. L’ipotesi dei nuovi controlli si basa sul fatto che le persone contagiate non abitano nella stessa zona di Bresso, motivo per cui non si esclude che la sorgente possa trovarsi in un luogo molto frequentato. I prelievi finora effettuati dall’acquedotto non hanno portato a trovare traccia dell’agente scoperto nel 1976 dopo che aveva provocato 34 morti tra i veterani della American Legion riuniti a Filadelfia. Non è la prima volta che a Bresso viene registrata una situazione simile. Nel 2014 vi erano stati sei casi (di cui uno mortale) di legionella. Allora si erano però manifestati nell’arco di alcuni mesi. È noto, evidenzia Giovanni D’Agata, presidente dello “Sportello dei Diritti”, che la malattia si sviluppa rapidamente in presenza di condizioni particolari, e altrettanto rapidamente può scomparire, ma è pur vero che vi sono luoghi dove è più facile che il batterio si annidi e proliferi, come quando vi sono impianti di condizionamento dell’aria o cisterne di approviggionamento dell’acqua. La legionella si può trovare ovunque però, poichè predilige habitat acquatici caldi, tra i 25 e i 45 gradi. In genere il batterio può colonizzare tutti gli ambienti acquatici artificiali, gli impianti idrici, di umidificazione e condizionamento. Ovunque ci sia acqua calda c’è il rischio di trovare la legionella, ma i luoghi con acqua calda nebulizzata sono i più pericolosi. Casi di legionellosi sono stati segnalati in ospedali, case di cura, studi odontoiatrici, alberghi, campeggi, impianti termali e ricreativi (palestre, piscine, idromassaggi), giardini e campi da golf con sistemi di irrigazione a spruzzo e/o fontane decorative, navi da crociera. Gli alberghi, per esempio, sono spazi ove nella pressoché generalità dei casi vi sono tali tipi d’impianti o serbatoi. È ovvio che un’adeguata manutenzione può limitare di gran lunga i rischi di proliferazione della legionella. Controlli che non sempre sono puntuali ed efficaci. Ecco perché le autorità sanitarie, specie nei luoghi pubblici o aperti al pubblico, dovrebbero aumentare le attività di verifica al fine d’impedire sul nascere l’eventuale diffusione della temibile infezione.
